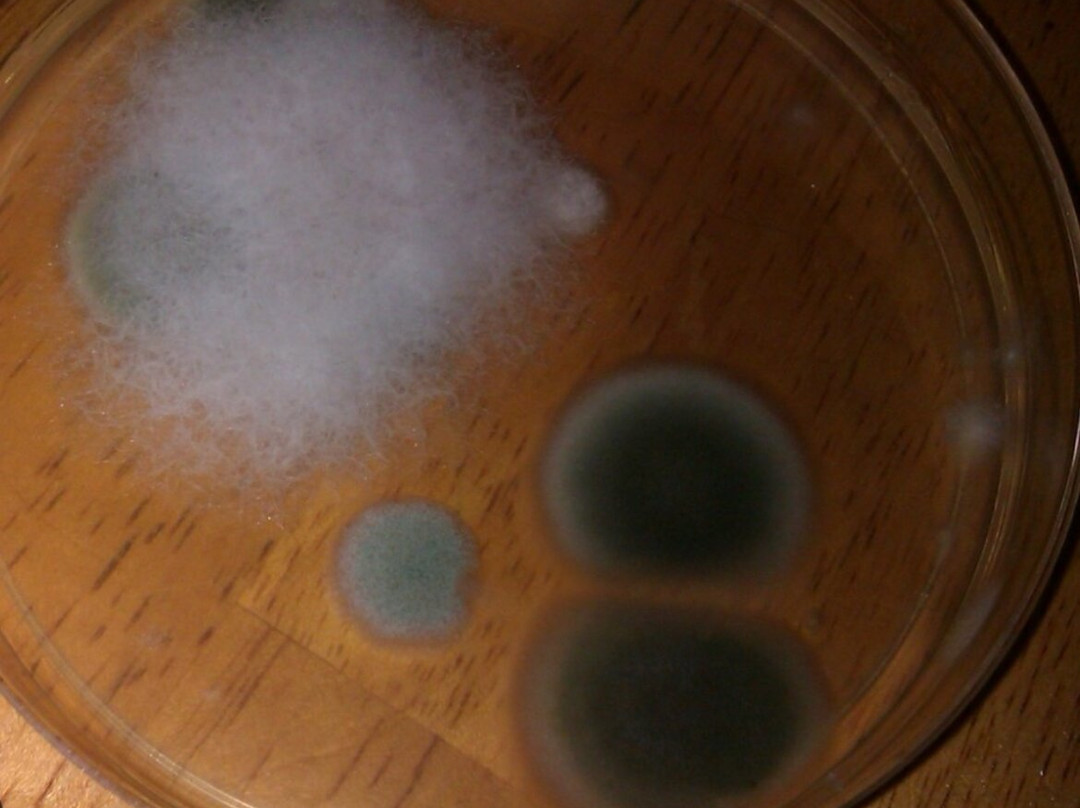
Extended Stay America Select Suites - Lake Worth主图

关于
莱克沃思排名第 3 的酒店(共 10 个)
简介
美国长住精选套房酒店 - 莱克沃思坐落于雷克沃思中心地段,距离城市广场和棕榈滩县会议中心不到 10 分钟车程。 此酒店距离棕榈海滩港 12.5 英里(20.1 公里),距离莱克沃思海滩 3.4 英里(5.4 公里)。 您可利用免费 WiFi和自动售货机等便利服务和设施。 特色服务/设施包括快速退房、洗衣设施和电梯。酒店提供免费自助停车。 有 124 间客房提供备有大冰箱和炉灶的厨房;您定能在旅途中找到家的舒适。带有有线频道的 34 英寸平板电视可满足您的娱乐需求;同时提供免费无线网络,方便您与朋友保持联系。便利设施包括电话,以及书桌和独立的起居区。
阅读更多
酒店设施
家庭房
无障碍客房
吸烟房
套房
免费停车
免费Wifi
显示更多
酒店信息
酒店钻级
二钻
酒店风格
家庭
位于中心地带
这是您的 Tripadvisor 详情页吗?
拥有或管理这家酒店? 免费获取您的详情页以便回复点评、更新资料或者进行其他操作。
获取详情页

沪公网安备31010502005427号
沪公网安备31010502005427号